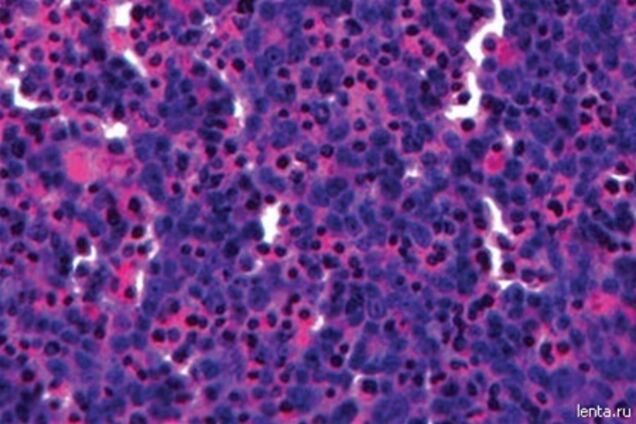
Ученые 'напечатали' мини-печень на 3D-принтере

Ученые "напечатали" мини-печень на 3D-принтере
Сотрудники американской компании Organovo научились создавать небольшие искусственные фрагменты печени, используя для этого 3D-принтер. О результатах работы над технологией на конференции в Бостоне рассказал исполнительный директор компании Кейт Мёрфи, передает Lenta.ru.
Ткань создается на 3D-принтере аналогично обычной струйной печати, однако вместо различных красок используются разные типы клеток. Для создания искусственной печени специалисты использовали три типа клеток печени: гепатоциты, звездчатые клетки (клетки Ито) и, в небольшом количестве, клетки эпителия, выстилающего кровеносные сосуды.
Полученные печатью искусственные ткани предназначены для тестирования лекарств, поэтому они создаются в лунках на дне стандартных клинических планшетов. По форме фрагменты печени представляли собой небольшие диски диаметром около 4 миллиметров. Гепатоциты уложены в них приблизительно в 20 слоев.
Как показал анализ, клетки в искусственной ткани начинают образовывать полноценные контакты, производить альбумин и цитохромы, а также выполнять другие функции печени.
По словам создателей, трехмерная искусственная ткань отличается от обычной клеточной культуры более "правдоподобной" реакцией в клинических тестах. Кроме того, она способна автономно существовать целых пять дней, в то время как культуры клеток требуется пересевать каждые два-три дня.










